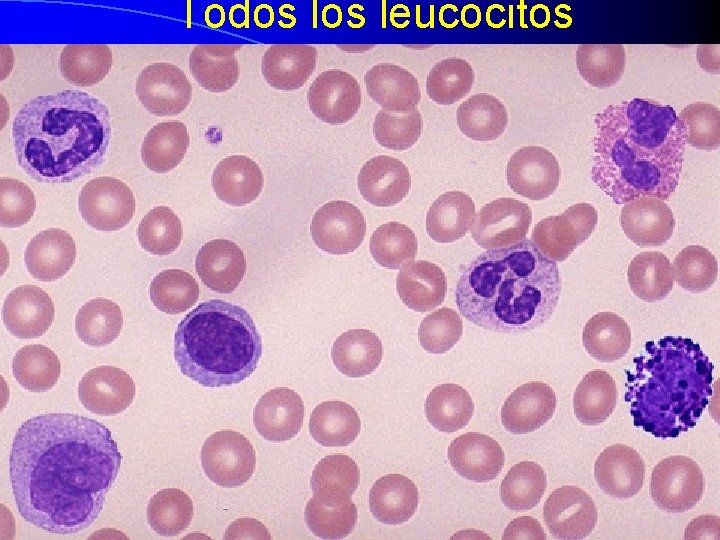
Todos leucocitos
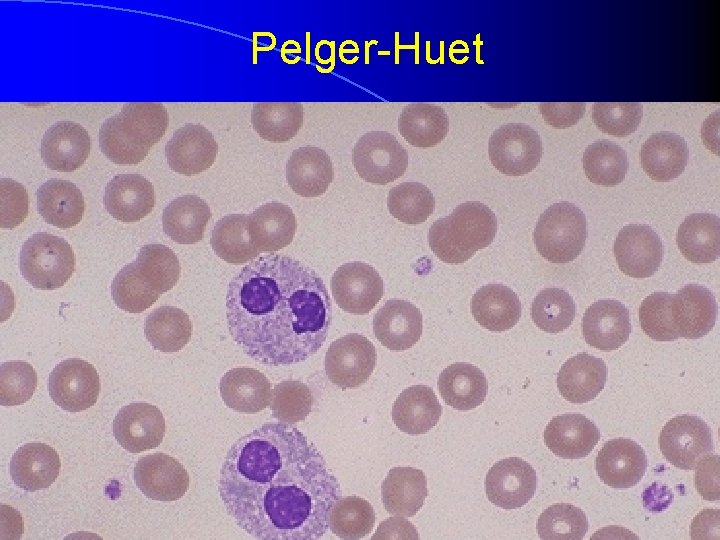
Pelger-Huet
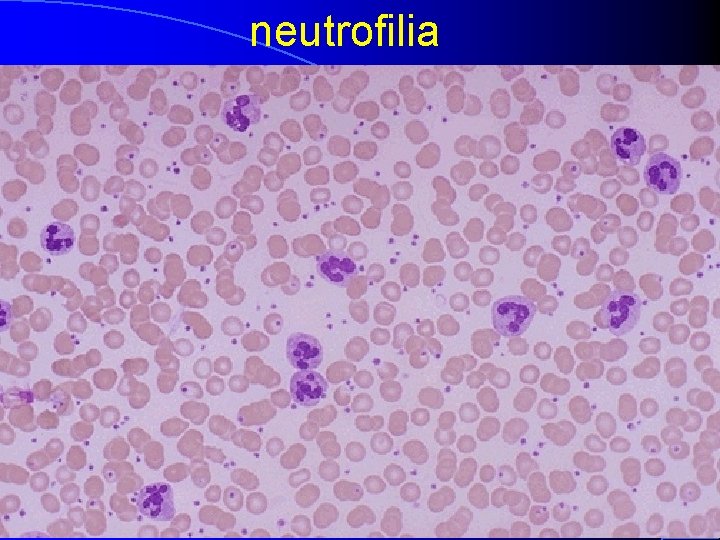
neutrofilia

CAPTULO 6 l Leucocitos y leucopoyesis l Mtodos













- Slides: 13

CAPÍTULO 6 l Leucocitos y leucopoyesis l Métodos de laboratorio para el estudio de los trastornos leucocitarios l Alteraciones no neoplásicas, cualitativas y cuantitativas, de los leucocitos
Todos leucocitos


SENSIBILIDAD DE TÉCNICAS l 1/100 células: examen patológico/citogenética l 1/1000 células: FACS l 1/100. 000 células: PCR

Valores normales l Leucocitos (x 109/l) 7. 5 (adulto) – Leucocitosis – Leucopenia l Neutrófilos: l Linfocitos l Eosinófilos l Basófilos l Monocitos 9 -18 (niños) > 11 <4 2 – 7. 5 1. 5 -4. 0 0. 04 -0. 4 <0. 04 -0. 4 0. 2 -1 (40 -75%) (20 -45%) (1 -6%) (< 1%) (2 -10%)

Anomalías cuantitativas l l l l Neutrofilia > 7. 5 x 109 Linfocitosis > 4. 5 x 109 Monocitosis > 1. 0 x 109 Eosinofilia > 0. 5 x 109 Niños: Linfocitos: 5. 5 - 8. 5 x 109 Neutrófilos: 2. 0 -6. 0 x 109 Neutropenia < 1 x 109 l Linfopenia < 1 x 109 l Monocitopenia < 0. 2 x 109 l
Pelger-Huet
neutrofilia

Causas de neutropenia l producción neutrófilos – Citotóxicos, leucemia, aplasia medular, falta de B 12 o ácido fólico l Destrucción o eliminación acelerada – Reacciones autoinmunes: idiopáticas, lupus o fármacos (independiente de dosis) – Depresores medulares: alquilantes y antimetabolitos (dosis-dependiente) – Reacciones idiosincráticas a fármacos l↑ utilización en la periferia (infecciones arrolladores)

linfocitosis l Reactivas (policlonales) – Mononucleosis infecciosa – Stress – Artritis reumatoide l Leucemia linfocítica/linfoma (monoclonales) l Niños: hasta 22 x 109/L linfocitopenia Congénitas l Adquiridas: radiación, quimioterapia, inmunosupresores, glucocorticoides… l

Anomalías de los leucocitos l Cuantitativas: leucopenia/leucocitosis l Cualitativas – Déficit de NADPHox o MPO – Anomalías en la desgranulación, quimiotaxis o adhesión


Déficit de adhesión leucocitaria 1 (cadena ß integrinas) Déficit de adhesión leucocitaria 2 (receptor de la selectina) Chediak-Higashi W. B. Saunders Company items and derived items Copyright (c) 1999 by W. B. Saunders Company